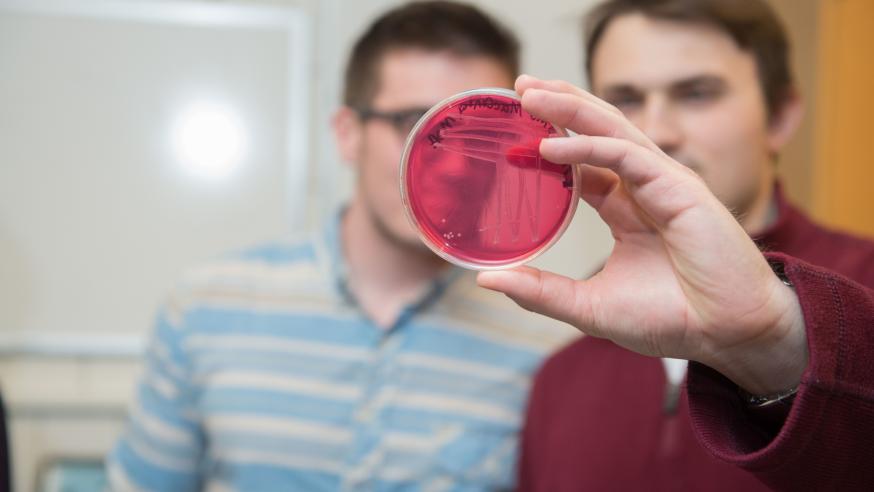
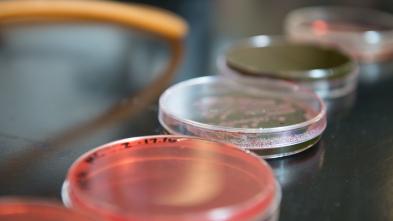

Public Health Graduate Certificate
Build a strong foundation in public health.
Improve Lives
Public health saves and improves millions of lives every day. Through science-based and evidence-backed initiatives, public health promotes and protects the health of populations and environments locally, nationally, and around the world.
Program Details
Blugold Stories
JustThe Facts
Our 12-credit hour, 100% online graduate certificate program gives you the skills needed to develop broad-based, collaborative strategies for solving public health challenges with an evidence-based approach. In addition to the two core courses, you’ll choose two elective courses to personalize your professional development.
Here are a few courses in Public Health Graduate Certificate at UW-Eau Claire.
PH 710
Foundations and Applications of Public Health
Examines purpose, organization, and functions of public health systems and the factors and determinants affecting population health.
PH 725
Principles of Epidemiology
Descriptive and analytical epidemiological methods used in public health practice. Emphasizes application, interpretation, and epidemiological literacy.
PH 715
Environmental and Occupational Health
This course investigates physical, chemical and biological hazards in food, air, water and soil associated with adverse human health effects. Exposure to hazards among the general population and in occupational settings will be explored. Students will learn approaches to mitigating risk and environmental contamination. The course introduces students to careers in Environmental Occupational Health.
Get More Info
Sign up to receive additional information about our campus.
Meet the Faculty